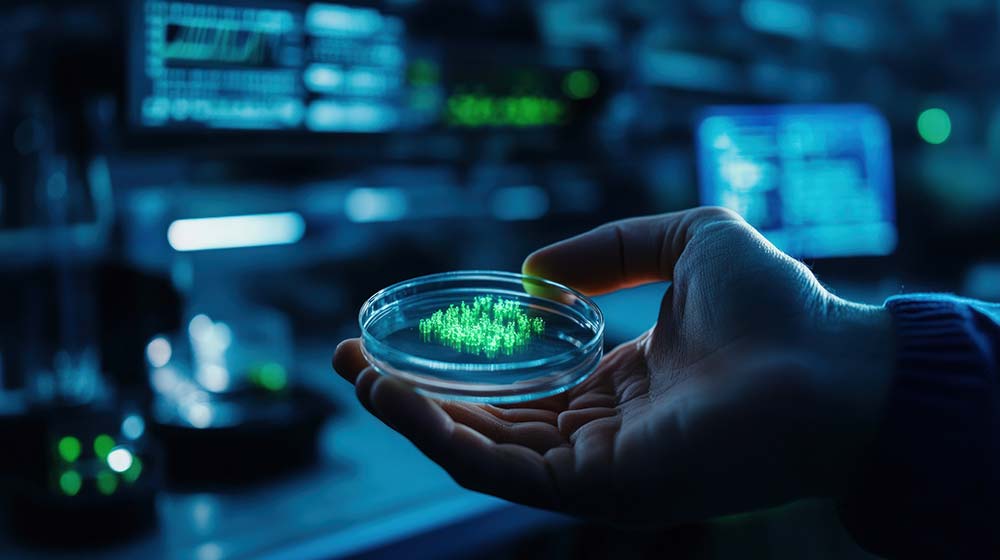

封面报道
沟通的断绝:
细胞间通讯改变如何导致机体失调?
2026年01月12日 08:40

想象一下,一座运转良好的现代化大都市。居民楼、发电厂、污水处理厂、警察局、消防队各司其职,而确保这一切协同工作的,是错综复杂且高效的信息网络:电话、互联网、交通信号、广播系统。一旦这些通讯系统出现大规模故障,信息无法传递,指令无法下达,整座城市将在短时间内陷入瘫痪:电网崩溃、交通拥堵、物资短缺、社会失序。
我们的身体,正是一个由数十万亿个“公民”——细胞——组成的、远比任何城市都精密的“超级社会”。每一个组织、器官都是一个功能特区,而确保这个庞大社会和谐运转的基石,便是细胞间通讯。这是细胞通过化学信号(激素、细胞因子)、电信号(神经元)、直接接触(间隙连接)或机械信号等方式,进行信息交换、协调运作的生命过程。正是依靠这套精密的通讯网络,心跳得以规律、血糖得以稳定、伤口得以愈合、免疫系统得以精准打击入侵者。
然而,与任何复杂的系统一样,这套通讯网络也会随着年龄增长、环境压力而逐渐退化、失真甚至被恶意干扰。细胞间通讯的改变,并非简单地“信号变弱”,而更像是一场交织着信号缺失、噪音干扰、错误指令和恶意广播的“通讯灾难”。它被认为是衰老和众多慢性疾病的核心驱动力。2013年发表于《细胞》杂志的里程碑式综述《衰老的标志》中,就将“细胞间通讯改变”列为九大核心衰老标志之一,强调了其在驱动机体系统性功能衰退中的中心地位。
本文将深入探讨细胞间通讯这一生命“社交网络”的核心规则,剖析其随年龄增长而失灵的多种原因与形式,并详细阐述这种“沟通断绝”如何像推倒多米诺骨牌一样,引发从慢性炎症、代谢紊乱到神经退行性疾病等一系列机体失调。最后,我们将基于最新的科学研究,梳理出一份旨在修复和优化细胞间通讯、维护机体内部“和谐社会”的实用策略指南[3]。

细胞并非孤立的存在。它们通过一套高度进化、形式多样的“通讯协议”进行对话,以确保机体的整体性和适应性。这些通讯方式主要包括内分泌、旁分泌、自分泌、神经信号、直接接触等。在衰老和疾病背景下,以下几种通讯方式的紊乱尤为关键:
神经内分泌通讯失调
激素“信使”的紊乱
内分泌系统是典型的远程通讯系统,激素作为化学信使,由腺体分泌进入血液循环,作用于远端的靶细胞,调控代谢、生长、应激和繁殖等基本生命活动。随着年龄增长,这一系统的精确性逐渐丧失。
下丘脑-垂体-靶腺轴功能减退:例如,生长激素(GH)/胰岛素样生长因子-1(IGF-1)轴的活性随年龄显著下降,这与肌肉减少、脂肪增加、组织修复能力减弱密切相关。同样,性腺轴(如雌激素、睾酮)的衰退直接驱动更年期症状和与性别相关的衰老表型。
胰岛素抵抗:这是一种典型的信号接收端故障。靶细胞(如肌肉、肝脏、脂肪细胞)对胰岛素信号“听而不闻”或反应迟钝,导致血糖调控失灵。胰岛素本身是一种关键的内分泌激素,其信号通路(如PI3K-Akt)也是细胞感受营养状态、调节自噬和代谢的核心通路。胰岛素抵抗不仅是2型糖尿病的核心,更被视为加速全身性衰老的元凶之一,因为它与慢性炎症、线粒体功能障碍等广泛交织。

炎症通讯的失控
从警报到暴乱
在急性情况下,促炎细胞因子(如TNF-α, IL-1β, IL-6)是重要的警报信号,召集免疫细胞清除威胁。但在衰老过程中,这种急性、可控的炎症反应,转变为慢性、低度、系统性的炎症状态,称为 “炎性衰老”。
衰老相关分泌表型(SASP):这是衰老细胞最突出的“恶意广播”。当细胞因DNA损伤、端粒缩短等原因进入衰老状态后,它们并未死亡,而是持续分泌大量的促炎因子、趋化因子、生长因子和蛋白酶。SASP就像一个持续的、失真的警报,不断污染局部微环境,破坏组织结构,并通过血液循环将炎症信号扩散至全身。SASP是连接细胞衰老与机体衰老的关键环节,直接驱动慢性炎症、损害干细胞功能、并促进邻近细胞衰老。
免疫系统衰老:免疫细胞本身的功能衰退和通讯紊乱加剧了炎性衰老。例如,初始T细胞减少、记忆T细胞扩张、免疫细胞对病原体反应迟钝,同时却对自身抗原产生低度反应,导致自身免疫倾向增加和清除衰老细胞能力下降,形成恶性循环。
机械信号与间隙连接通讯的衰减
失去的“触觉”与“局域网”
细胞不仅能“听”化学信号,还能“感觉”物理环境,并通过直接连接进行快速信息交换。
细胞外基质(ECM)-整合素信号:细胞通过表面的整合素蛋白感知ECM的刚度、拓扑结构等机械信号,并将这些信息转化为调控细胞增殖、分化和迁移的生化信号。ECM的衰老变化(如胶原交联、弹性丧失)会发送错误的机械信号,影响细胞行为。反之,衰老细胞的SASP也会破坏ECM,形成一个破坏性的反馈回路。
间隙连接通讯减少:间隙连接是相邻细胞膜上的通道蛋白(如连接蛋白),允许小分子、离子和第二信使(如钙离子、cAMP)直接、快速地在细胞间传递。这种通讯对于电兴奋组织(如心肌的同步收缩、神经元间的信息传递)和协调组织代谢反应至关重要。研究表明,随着年龄增长,连接蛋白的表达和功能普遍下降,导致组织协调性变差,这在心脏传导障碍和认知功能下降中可能扮演重要角色。


细胞间通讯网络的退化是多种内在和外在因素共同作用的结果,它们从信号的生产、发送、传输到接收、解码的各个环节进行破坏。
内在衰老程序:核心“发射塔”与“接收器”的耗损
衰老细胞的累积与SASP:如上所述,衰老细胞是炎症噪音的主要来源。随着年龄增长,由于端粒损耗、DNA损伤累积等原因,衰老细胞在多种组织中逐渐积累,其分泌的SASP成为破坏通讯稳态的核心因素。
干细胞与祖细胞功能衰退:干细胞是组织修复和再生的源泉,它们依赖于精确的微环境信号(生态位)来维持静息、分化或自我更新。随着年龄增长,生态位信号发生改变(如炎症因子增加、支持性信号减少),同时干细胞自身的信号响应能力下降,导致其再生潜能耗竭,无法有效补充功能性细胞,组织稳态难以维持。
表观遗传噪音:表观遗传修饰(如DNA甲基化、组蛋白修饰)是调控基因表达的重要“开关”,决定了细胞对特定信号如何响应。衰老过程中,表观遗传图谱会出现全基因组的紊乱(如整体低甲基化与特定区域高甲基化),增加基因表达的“噪音”,降低细胞身份的特异性和信号响应的精确度。这好比通讯频段被杂音干扰,重要指令变得模糊不清。

外在环境压力
对通讯网络的持续“干扰”与“攻击”
慢性代谢压力与营养过剩:长期高热量饮食导致的肥胖和胰岛素抵抗,是破坏全身性激素和代谢通讯的最主要生活方式因素。游离脂肪酸、高血糖本身就能激活固有免疫细胞(如脂肪组织中的巨噬细胞),促使其分泌促炎因子,引发慢性低度炎症,干扰正常的代谢信号传导[5]。
环境毒素与氧化应激:空气污染物(如PM2.5)、环境内分泌干扰物、烟草烟雾等,可以直接损伤细胞,诱导氧化应激和炎症反应,或模拟/拮抗内源性激素(如雌激素、甲状腺激素),从而扰乱内分泌通讯。
肠道菌群失调:肠道菌群与宿主之间存在着极其活跃的化学对话。菌群代谢产生的短链脂肪酸、胆汁酸、色氨酸衍生物等,能直接影响宿主的免疫系统、代谢和大脑功能。衰老伴随的菌群多样性下降和有害菌增多(生态失调),会导致这些信号分子的谱系发生改变,例如促炎脂多糖(LPS)入血增加,而具有抗炎作用的丁酸盐减少,从而加剧全身的炎性衰老和代谢紊乱。
社会心理压力:长期的心理压力通过激活下丘脑-垂体-肾上腺轴,导致糖皮质激素(如皮质醇)持续升高。慢性的高水平皮质醇会促进胰岛素抵抗、抑制免疫功能、甚至损害海马体神经元,是一种强大的、由大脑发起的、能扰乱全身多系统通讯的生理压力信号。


鉴于细胞间通讯改变在衰老中的核心地位,针对性地修复和优化这一网络,成为延缓衰老、防治慢性疾病的前沿策略。干预可以从减少通讯干扰、增强有益信号和清除干扰源等多个层面入手。
生活方式干预
减少“通讯噪音”,增强“信号强度”
饮食模式:
热量限制与间歇性禁食:这是目前已知最强效的、能系统性改善细胞间通讯的干预措施。它们通过降低胰岛素/IGF-1信号活性、激活AMPK和sirtuins等长寿通路、减轻氧化应激和炎症、优化线粒体功能、改善自噬等多重机制,重塑代谢和炎症信号网络。研究表明,这些干预能显著延长多种模式生物的寿命和健康寿命。
抗炎/抗氧化饮食:采用地中海饮食等模式,富含omega-3脂肪酸(鱼类)、多酚(蔬菜水果、绿茶、橄榄油)、膳食纤维(全谷物、豆类)。这些成分能直接抑制NF-κB等促炎信号通路,增加抗炎介质(如脂联素)的产生,并作为抗氧化剂保护信号分子免受破坏。
规律运动:运动是一种全身性的“信号重置”过程。它能显著改善胰岛素敏感性,促进肌肉释放具有抗炎和代谢益处的肌因子(如鸢尾素),降低循环中促炎细胞因子水平,并可能刺激脑源性神经营养因子(BDNF)的释放,改善神经通讯。无论是耐力运动还是抗阻运动,均被证实对优化通讯网络至关重要。
压力管理与优质睡眠:通过冥想、正念、瑜伽等方式管理压力,可以降低皮质醇水平,减轻其对通讯网络的干扰。充足的深度睡眠对于清除大脑代谢废物(如通过类淋巴系统)、稳定激素节律(如生长激素)、调节免疫功能和巩固记忆相关的神经连接都必不可少,是维持通讯网络夜间“维护检修”的关键窗口。
营养补充与药物干预
提供“信号原料”与“信号调节器”
NAD+前体(NMN/NR):烟酰胺腺嘌呤二核苷酸(NAD+)是sirtuins等长寿蛋白发挥去乙酰化功能所必需的辅因子,sirtuins则参与调控代谢、应激抵抗、炎症和昼夜节律等多种通讯通路。随着年龄增长,组织NAD+水平下降。补充其前体烟酰胺单核苷酸(NMN)或烟酰胺核糖(NR),在临床前研究中被证明能提升NAD+水平,改善代谢健康、血管功能和神经通讯,部分临床试验也显示出积极前景。
二甲双胍:这种经典降糖药的作用机制复杂,其中就包括激活AMPK(能量传感器)、抑制mTOR(营养传感器)、减轻线粒体氧化应激和抑制炎症反应。这些作用共同指向改善代谢和炎症通讯。其潜在的抗衰老效应正通过大规模临床试验(如TAME试验)进行验证。
Senolytics(衰老细胞清除剂):这是一类新兴的药物策略,旨在选择性诱导衰老细胞凋亡,从而从根源上消除SASP这一最大的炎症噪音源。达沙替尼和槲皮素(D+Q)的组合在临床前模型中成功清除了衰老细胞,改善了多种衰老相关病症。早期人体临床试验也显示出安全性和改善某些指标的潜力,是极具前景的“通讯清道夫”。
益生菌/益生元/后生元:通过补充特定的有益菌(益生菌)、促进有益菌生长的膳食成分(益生元)或直接补充有益菌的代谢产物(后生元,如丁酸盐),可以旨在纠正肠道菌群失调,恢复健康的肠道-宿主对话,从而间接改善全身的免疫和代谢通讯。
新兴技术展望
精准的“信号修复”
基因与细胞疗法:未来可能通过基因编辑技术纠正导致通讯障碍的关键基因突变,或通过干细胞移植补充功能衰退的细胞群体,重建健康的组织微环境和信号网络。例如,将经过基因修饰以抵抗衰老或增强功能的干细胞回输体内,以恢复组织的正常通讯和功能。


衰老,远不止是单个细胞的磨损,它更像是一场席卷全身的“通讯危机”。从激素信号的衰减、炎症警报的误鸣,到细胞间直接对话的沉寂,这场危机逐渐瓦解了机体数十万亿细胞间精妙协作所构建的生命秩序。
然而,与固定不变的基因硬件不同,细胞间通讯是一个动态的、可塑的“软件系统”。这为我们干预衰老进程提供了充满希望的切入点。我们每日的餐桌选择、活动水平、睡眠质量和情绪管理,都在无形中编写着指令,或向我们的细胞社会发送着和谐或混乱的信号。
理解细胞间通讯,就是理解生命作为复杂系统的本质。它告诉我们,健康不是单个器官的孤立强健,而是全身网络的高效、和谐对话。当我们选择一顿富含抗炎物质的餐食,进行一次激活全身信号的运动,或者有效地管理一次压力时,我们不仅是在关爱某个器官,更是在为我们身体内部的整个“社交网络”进行维护和升级,为长久地维持生命的协调与活力奠定基石。这场始于微观细胞对话的维护,最终将决定我们在宏观世界中生命的质量与韵律。
参考文献及出处:
[1] Alberts, B., Johnson, A., Lewis, J., et al. (2002). Molecular Biology of the Cell. 4th edition. Chapter 15: Cell Signaling. Garland Science.
[2] López-Otín, C., Blasco, M. A., Partridge, L., Serrano, M., & Kroemer, G. (2013). The hallmarks of aging. Cell, 153(6), 1194-1217.
[3] Kennedy, B. K., Berger, S. L., Brunet, A., et al. (2014). Geroscience: linking aging to chronic disease. Cell, 159(4), 709-713.
[4] Bartke, A. (2019). Growth hormone and aging: updated review. The World Journal of Men's Health, 37(1), 19-30.
[5] Barzilai, N., Huffman, D. M., Muzumdar, R. H., & Bartke, A. (2012). The critical role of metabolic pathways in aging. Diabetes, 61(6), 1315-1322.
[6] Coppé, J. P., Desprez, P. Y., Krtolica, A., & Campisi, J. (2010). The senescence-associated secretory phenotype: the dark side of tumor suppression. Annual Review of Pathology: Mechanisms of Disease, 5, 99-118.
[7] Goronzy, J. J., & Weyand, C. M. (2019). Mechanisms underlying T cell ageing. Nature Reviews Immunology, 19(9), 573-583.
[8] Theocharis, A. D., Skandalis, S. S., Gialeli, C., & Karamanos, N. K. (2016). Extracellular matrix structure. Advanced Drug Delivery Reviews, 97, 4-27.
[9] Goodenough, D. A., & Paul, D. L. (2009). Gap junctions. Cold Spring Harbor Perspectives in Biology, 1(1), a002576.
[10] Oh, J., Lee, Y. D., & Wagers, A. J. (2014). Stem cell aging: mechanisms, regulators and therapeutic opportunities. Nature Medicine, 20(8), 870-880.
[11] Benayoun, B. A., Pollina, E. A., & Brunet, A. (2015). Epigenetic regulation of ageing: linking environmental inputs to genomic stability. Nature Reviews Molecular Cell Biology, 16(10), 593-610.
[12] Mostafalou, S., & Abdollahi, M. (2013). Pesticides and human chronic diseases: evidences, mechanisms, and perspectives. Toxicology and Applied Pharmacology, 268(2), 157-177.
[13] Ragonnaud, E., & Biragyn, A. (2021). Gut microbiota as the key controllers of “healthy” aging of elderly people. Immunity & Ageing, 18, 2.
[14] McEwen, B. S. (2007). Physiology and neurobiology of stress and adaptation: central role of the brain. Physiological Reviews, 87(3), 873-904.
[15] de Cabo, R., & Mattson, M. P. (2019). Effects of intermittent fasting on health, aging, and disease. New England Journal of Medicine, 381(26), 2541-2551.
[16] Calder, P. C., Bosco, N., Bourdet-Sicard, R., et al. (2017). Health relevance of the modification of low grade inflammation in ageing (inflammageing) and the role of nutrition. Ageing Research Reviews, 40, 95-119.
[17] Pedersen, B. K., & Saltin, B. (2015). Exercise as medicine – evidence for prescribing exercise as therapy in 26 different chronic diseases. Scandinavian Journal of Medicine & Science in Sports, 25(S3), 1-72.
[18] Irwin, M. R. (2019). Sleep and inflammation: partners in sickness and in health. Nature Reviews Immunology, 19(11), 702-715.
[19] Yoshino, J., Baur, J. A., & Imai, S. I. (2018). NAD+ intermediates: the biology and therapeutic potential of NMN and NR. Cell Metabolism, 27(3), 513-528.
[20] Barzilai, N., Crandall, J. P., Kritchevsky, S. B., & Espeland, M. A. (2016). Metformin as a tool to target aging. Cell Metabolism, 23(6), 1060-1065.
[21] Kirkland, J. L., & Tchkonia, T. (2020). Senolytic drugs: from discovery to translation. Journal of Internal Medicine, 288(5), 518-536.
[22] Villeda, S. A., Plambeck, K. E., Middeldorp, J., et al. (2014). Young blood reverses age-related impairments in cognitive function and synaptic plasticity in mice. Nature Medicine, 20(6), 659-663.
[23] Mahmoudi, S., Xu, L., & Brunet, A. (2019). Turning back time with emerging rejuvenation strategies. Nature Cell Biology, 21(1), 32-43.
本文由山东大学齐鲁医学院教授、博士生导师郝爱军复核。Bioπ中国美肤科学传播平台发布本文只是为了更多的信息参考,不代表任何有倾向性的投资意见或市场暗示。
THE END

京公网安备11010502058609号





















